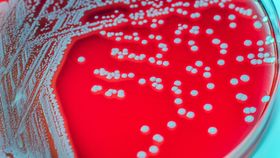
article image

A rising number of European Covid-19 cases suggest a possible link between childhood cases of the respiratory disease and two rare, potentially life-threatening conditions.
The rest of this article is behind a paywall. Please sign in or subscribe to access the full content.Over the last three weeks, European pediatricians are reporting a growing number of Covid-19 cases in children presenting with a multi-system hyperinflammatory state that overlaps with features of toxic shock syndrome (TSS) and Kawasaki disease, according to a post shared by the UK Paediatric Intensive Care Society (PICS). No such links have been reported in the US, reports Reuters.
Generally speaking, it appears that children experience much more mild symptoms associated with SARS-CoV-2 infection. The PICS notes that “serious illness as a result of COVID 19 still appears to be a very rare event in children” and the National Health Service calls it an “unusual clinical picture.” The alert indicated that “the cases have in common overlapping features of toxic shock syndrome and atypical Kawasaki disease with blood parameters consistent with severe COVID-19 in children. Abdominal pain and gastrointestinal symptoms have been a common feature as has cardiac inflammation.”
“There is a growing concern that a SARS-CoV-2 related inflammatory syndrome emerging in children in the UK or that there may be another as yet unidentified infectious pathogen associated with these cases,” according to a Tweet shared by PICS.
TSS is a rare but life-threatening condition that is associated with certain types of bacterial infections such as Staphylococcus aureus, or Staph, according to the Mayo Clinic. Symptoms of TSS overlap with some of those presented in Covid-19 cases, including sudden high fever, muscle aches, and headaches. Researchers have also presented a potential link between Covid-19 and Kawasaki disease, an inflammation of blood vessel walls and the leading cause of acquired heart disease in children in developed countries.
The report, which has not been peer-reviewed, describes a 6-month-old infant that presented with Covid-19 symptoms three weeks after her 9-year-old sibling had similar respiratory symptoms. It has since become what is thought to be the first described case of Kawasaki disease running concurrently with a mild presentation of Covid-19 infection. (Similarly, a 2005 case study presented a link between a novel human coronavirus dubbed “New Haven coronavirus” with Kawasaki disease in another 6-month-old infant.)
It is unclear whether these various diseases and infections are caused by Covid-19 or are simultaneously occurring infections that may be heightened by suppressed immunity and SARS-CoV-2 infection. Other reported symptoms associated with Covid-19 include foot lesions in children and some adults, as well as a sudden loss of smell and rare cases of brain inflammation.
Parents are encouraged to seek medical attention under guidelines previously set forth by experts. Medical professionals suggest that doctors discuss and report any such cases with a pediatric infectious disease expert or pediatric critical care teams.